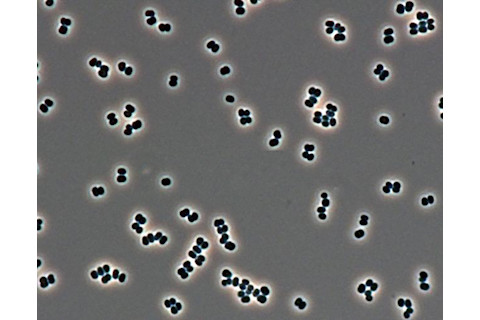

人类只在太阳系中两个星球上行走过——地球和它的月球。但火星很可能成为这个专属俱乐部的新成员。除了 NASA,SpaceX 和 Mars One 等私人公司也迫不及待地想把人类送上这颗红色星球。载人探索无疑可以改进在火星上进行的科学研究,但我们的到来也可能对寻找生命产生重要影响。
生命是否曾在地球的红色邻居上进化,至今仍是悬而未决的问题。火星的条件不支持大型生物,但微小的生命形式可能曾在该行星的海洋中繁盛。它们甚至可能至今仍幸存于火星地表和地表以下稀疏的水体中。如果是这样,它们可能与地球上的生命形式相似:生命可能通过搭乘小行星撞击从一个星球飞溅到另一个星球的岩石,从一个世界跳跃到另一个世界。
另一种可能性同样意义重大。如果火星是贫瘠的,而且研究人员发现生命仅在太阳系的一个行星上进化,这将揭示生命从一开始就产生有多么困难,并对整个宇宙产生影响。
但要解开“火星生命”之谜,存在一个自动的难题,一个固有的两难境地:任何着陆调查生命的宇航员都可能用他们自身的微生物污染该区域,从而不可能知道真相。NASA 长期以来一直有相关的协议来限制此类污染,但随着私人努力步伐的加快,以及人类真正抵达火星的可能性越来越大,这些标准可能不得不改变。

正如洛克希德·马丁公司在此插画中描绘的,未来登陆火星的宇航员面临着一个困境:如何在不造成损害的情况下研究外星生命?(图片来源:洛克希德·马丁)
洛克希德·马丁
史蒂夫·克利福德(Steve Clifford),一家非营利性行星科学研究所的高级研究科学家,认为任何未经认真预防措施的载人着陆都是坏消息。他说:“如果允许商业公司追求他们的议程,火星将在第一个人类踏上火星时被不可逆转地污染。” 目前,我们正处于野心和好奇心之间。
阻止蔓延
行星际污染是一个非常真实的问题。五十年前,阿波罗宇航员在月球旅行归来后被隔离;科学家们担心他们可能带回可能致命的物质,这些物质会在地球上传播。虽然这种恐惧很快就消除了,但未来的火星物质样本可能会携带危险的微生物。严格的隔离程序是为了尽量减少这种担忧。
更令人担忧,而且同样现实的是反向的可能性,即地球上的某些东西会污染火星。想象一下,如果红色星球上的仪器检测到一个生物,却无法确定它是源自火星还是悄悄地搭乘了未清洁好的宇航服,那将是多么令人困惑。“如果我们在人类历史上最伟大的发现中搞砸了怎么办?”亚利桑那州立大学的火星地质学家塔尼娅·哈里森(Tanya Harrison)说道。
克利福德指出了一个更糟糕的情况。如果红色星球上存在原生生命,但地球上的微生物却将其消灭了呢?他说:“在我们寻找生命的过程中,我们可能要为我们探测到的第一个外星生物圈的灭绝负责。”

NASA 在 20 世纪 70 年代对“维京”着陆器进行消毒。(图片来源:NASA)
美国宇航局
这是一个足够重要的问题,以至于联合国在 1967 年批准了《关于各国探索和利用外层空间(包括月球和其他天体)活动的原则条约》。NASA 的行星保护办公室完全赞同这一观点,并确保我们不破坏其他行星。工程师对航天器部件进行加热和清洁,行星保护团队对每个航天器的表面进行采样,以确保其符合高标准。例如,该办公室已确保每个火星探测器在暴露于火星环境的任何表面上携带的细菌孢子不超过 30 万个。(相比之下,人体大约携带 40 万亿个微生物。)
但所有这些工作都有成本。前 NASA 行星保护官约翰·鲁梅尔(John Rummel)估计,消毒工作的成本会使任务成本增加 14%,通常是数千万美元——这还只是探测器任务的费用。然而,他认为与永久污染火星的成本相比,这微不足道。不幸的是,将人类送上红色星球可能意味着将现有的行星保护规则抛诸脑后。
我们的身体,我们的细菌
当人类最终登陆火星时,无论如何,他们都会随身携带数万亿个微小“朋友”。即使我们能够承受销毁这些微生物伙伴所需的高温和强溶剂,没有它们我们也会死亡。
即使在洁净室中,Tersicoccus phoenicis 细菌也可能潜伏。(图片来源:NASA/JPL-Caltech)
NASA/JPL-Caltech
哈里森说:“我们的体内充满了细菌,因此完全保持环境的原始面貌是不可能的。” 这可能意味着要重新考虑消毒。“我们可以尽量小心,但我们必须接受,有一定程度的风险是人类在那里固有的。”
NASA 喷气推进实验室的项目经理布伦特·谢伍德(Brent Sherwood)也认为现在是时候改变了。在 2017 年亚利桑那州的一次天体生物学会议上,他认为需要重新审查行星保护规则,指出允许的污染水平自 1967 年以来没有改变,也没有跟上我们的技术和对生命的理解。“它已经 50 岁了,应该有一些活动来重新审视它,”他说。在同一次会议上,SETI 研究所的玛格丽特·雷斯(Margaret Race)也表示赞同:“我们正处于必须更新规则的时候。”
并非所有人都同意。鲁梅尔不认为需要改变规则,他认为即使人类探险者本身不干净,也可能保持一个地方的清洁。“规定是可以做到并且可以遵守的,”他说。“你必须理解它们最初存在的原因。”

“好奇号”探测器自 2012 年以来一直在安全地研究红色星球。(图片来源:NASA/JPL-Caltech)
NASA/JPL-Caltech
然而,即使目前的协议不需要改变,也不是每个人都像 NASA 那样小心。新墨西哥州洛斯阿拉莫斯国家实验室的行星地质学家妮娜·兰扎(Nina Lanza)说:“我认为(私人)公司正在突破界限、推动想法并激发人们的热情,这太棒了。”但她也担心,随着这些公司争相成为第一批将人类送上火星的公司,竞争将掩盖甚至损害科学进程。“这很棒,但我们没有真正需要的那么小心。”
禁止涉足水源
最终,我们如何以及在哪里寻找生命可能会塑造新的污染应对方法。鉴于水是我们所知生命的关键成分,富含该物质的环境被认为是最宜居的,因此它们将发挥关键作用。(虽然生命可能以一种意想不到的无水方式进化,但专注于进化已知遵循的路径更有意义。)
如今,只有经过最严格消毒的航天器才被允许探索富含水量的区域,NASA 将这些区域归类为“特殊区域”。大多数探测器无法达到要求。月球和行星研究所的大学空间研究协会的行星科学家埃德加德·里维拉-瓦伦丁(Edgard Rivera-Valentin)说:“凡是有水的地方,你都不能触碰或嗅闻。”

火星的地形图(蓝色代表低洼地区;红色代表高地)揭示了世界上多少地方是禁区:靠近水源的地方被称为“特殊区域”,探索需要额外的消毒。(图片来源:NASA 戈达德太空飞行中心)
NASA 戈达德太空飞行中心
如果 NASA 的清洁机器人根据目前的规定不能访问宜居区域,那么驾驶它们的人类探险者肯定也被排除在外。但“特殊区域”顾名思义,对寻找生命的科学家来说是最有趣的,当然,火星居民也需要水来生存。
鲁梅尔认为有一种方法可以满足所有人的需求。清洁的探测器可以采集冰并将其带回人类栖息地。“如果我们打算送人去火星,”里维拉-瓦伦丁说,“那应该去那些我们认为生命不可能存在的地方。”
另一种解决想要检查但又不破坏最脆弱的潜在生态系统之间的矛盾的方法是什么?就简单地等待。“如果火星现在有生命,那么 10 年、50 年、100 年后仍然会有生命,”克利福德说。当然,人类历史上最伟大的发现值得等待,同时我们可以改进消毒技术,并让机器人任务在此期间进一步勘探火星生物圈。
克利福德说:“我宁愿我们采取更慢、更周到的火星探索步伐,而不是不顾一切地以最低成本尽快发送载人飞船——在这个过程中,可能会对地球造成不可逆转的污染。”
Nola Taylor Redd 是一位专注于太空和天文学的自由科学记者。您可以在 Twitter 上找到她:@NolaTRedd。本故事最初以印刷版形式刊登,题为“保护火星免受……我们自己侵害”。

















